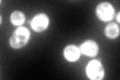
YGL195W
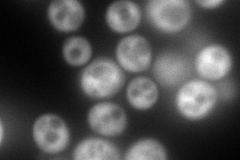
YGL195W
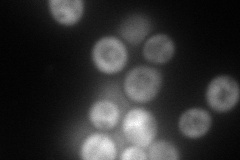
YGL195W
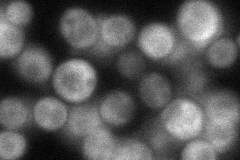
YGL195W
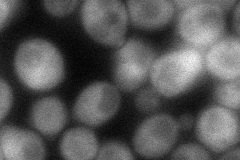
YGL195W

View description
Positive regulator of the Gcn2p kinase activity, forms a complex with Gcn20p; proposed to stimulate Gcn2p activation by an uncharged tRNA
Localization:
Intensity:
Fold change:
Significance:
-
C’ GFP library in SD
cytosol139.91 -
N' NOP1pr-GFP in SD
cytosol201.959 -
N' TEF2pr-mCherry in SD
cell periphery,bud neck193.284 -
N' NATIVEpr-GFP in SD
cytosol62.8312 -
N' TEF2pr-VC and Cyto-VN in SD
cytosol66.533 -
C’ GFP library in SD+DTT

cytosol130.180.93No -
C’ GFP library in SD+H2O2

cytosol127.670.91No -
C’ GFP library in Starvation Media

cytosol73.050.52Yes -
C’ GFP library on the background of Pup2-DaMP

cytosol -
C’ GFP library on the background of CCT mutant

cytosol168.431.20373No
